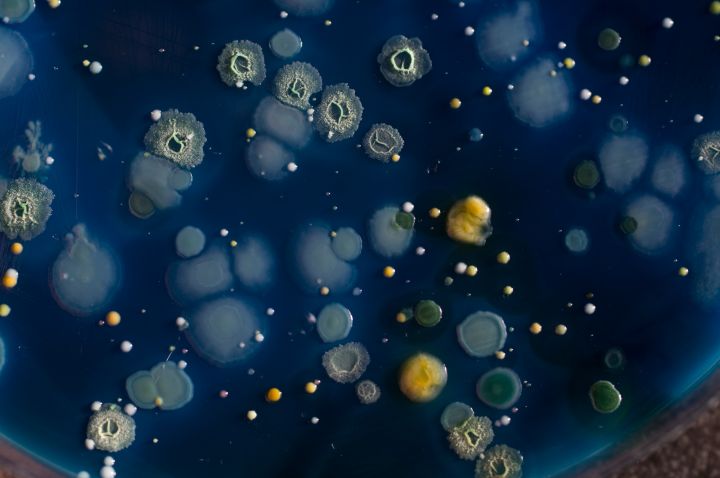

The gut microbiome is vital for survival and has been linked to digestion, brain and heart health, weight control, and reduced blood sugar.
Several diseases and autoimmune disorders are also thought to be influenced by processes in the gut microbiome including cancer, multiple sclerosis and autism spectrum disorder.
This discovery, led by scientists from La Trobe University, sheds new light on the developing foetal immune system, gut and brain.
Using extremely rigorous contamination controls, the researchers examined microbiome development along the gastrointestinal system in calves before birth. The innovative study, published in Nature’s Scientific Reports, reveals the microbiome is distinct along different components of the foetal gastrointestinal tract.
It the first study to completely eliminate the potential for microbial contamination, putting to rest the long-held theory that foetal development occurs in a sterile womb.
La Trobe University’s Professor Ashley Franks said the research turns this area of science on its head.
“The gut microbiome plays a major role in human health,” Professor Franks said.
“We know that from infancy to adulthood, trillions of microbial cells make up an essential part of our biology and physiological functions. They maintain the integrity of our gut lining and even protect us from disease and illness.
“Until now, the baby’s first gut microbiome was thought to be collected from the mother’s vagina or from the environment it’s born into. Our findings confirm, without doubt, that bacteria colonise in the gut before birth, changing the future of foetal research and our understanding of how the microbiome influences our developing immune system, gut and brain.”
The researchers identified 559 bacterial and 1736 discreet archaeal taxa through next generation sequencing of five components of the foetal gastrointestinal tract – ruminal fluid, ruminal tissue, caecal fluid, caecal tissue and meconium – and in the amniotic fluid.
Co-author Dr Jennifer Wood, from La Trobe’s Applied and Environmental Microbiology Lab, said the study showed distribution of these microorganisms across the gastrointestinal tract was not random, indicating the selection of our optimal microbiome is occurring in utero.
“We found tightly controlled microbial selection was occurring along the gastrointestinal tract and that this selection was the same in every calf we examined. We believe the reliability with which we observed the microbiome to develop shows gut microbiota are essential to foetal development,” Dr Wood said.
The findings are of major significance to humans because of the importance of the gut-brain axis, or gut microbiota signals to the brain, in development.
“These findings inform our ongoing research with Dr Elisa Hill at RMIT University. Together, we are studying the connection between the nervous system and microbes in neurodevelopmental disorders such as autism. The development of the gut in very early life and the role of the prenatal gut-microbiome could have far reaching consequence for human health,” Dr Wood said.
Media Contact: Kathryn Powley – k.powley@latrobe.edu.au – 0456 764 371